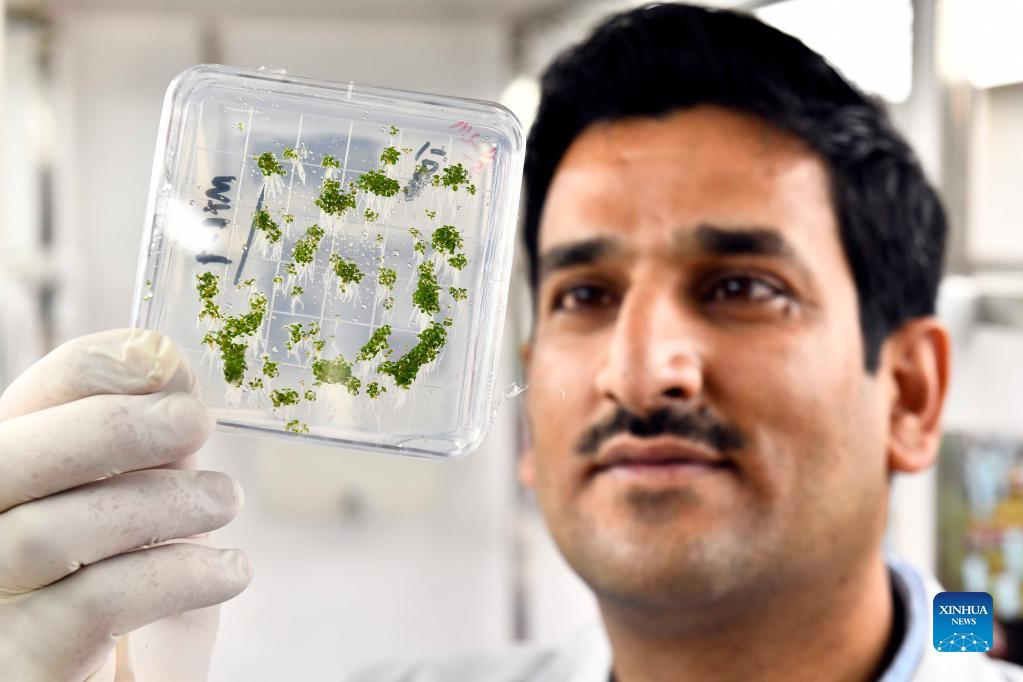

Pakistani student gets doctor's degree at Institute of Vegetables and Flowers of Chinese Academy

Dr. Anwar Ali (L) talks with a researcher at the Institute of Vegetables and Flowers of Shandong Academy of Agricultural Sciences in Jinan, east China's Shandong Province, Jan. 7, 2022. In 2016, Ali, a Pakistani student at that time, came to China and got his doctor's degree at the Institute of Vegetables and Flowers of Chinese Academy of Agricultural Sciences. In 2021, he came to Jinan for further study, conducting his post-doctoral research here. "Shandong is a major agricultural province in China, which also has the edge on agricultural technology," said Ali. He hopes to bring the advanced vegetable planting technology he has learned here back to Pakistan to help develop the agricultural industry of his homeland. Ali is glad that he can witness and disseminate China-Pakistan friendship with vegetable sciences. (Xinhua/Guo Xulei)

Dr. Anwar Ali (2nd L) poses for a group photo with researchers at the Institute of Vegetables and Flowers of Shandong Academy of Agricultural Sciences in Jinan, east China's Shandong Province, Jan. 7, 2022. In 2016, Ali, a Pakistani student at that time, came to China and got his doctor's degree at the Institute of Vegetables and Flowers of Chinese Academy of Agricultural Sciences. In 2021, he came to Jinan for further study, conducting his post-doctoral research here. "Shandong is a major agricultural province in China, which also has the edge on agricultural technology," said Ali. He hopes to bring the advanced vegetable planting technology he has learned here back to Pakistan to help develop the agricultural industry of his homeland. Ali is glad that he can witness and disseminate China-Pakistan friendship with vegetable sciences. (Xinhua/Guo Xulei)

Dr. Anwar Ali (R) studies in the tissue culture lab with his tutor Gao Jianwei at the Institute of Vegetables and Flowers of Shandong Academy of Agricultural Sciences in Jinan, east China's Shandong Province, Jan. 7, 2022. In 2016, Ali, a Pakistani student at that time, came to China and got his doctor's degree at the Institute of Vegetables and Flowers of Chinese Academy of Agricultural Sciences. In 2021, he came to Jinan for further study, conducting his post-doctoral research here. "Shandong is a major agricultural province in China, which also has the edge on agricultural technology," said Ali. He hopes to bring the advanced vegetable planting technology he has learned here back to Pakistan to help develop the agricultural industry of his homeland. Ali is glad that he can witness and disseminate China-Pakistan friendship with vegetable sciences. (Xinhua/Guo Xulei)

Dr. Anwar Ali (1st R) talks with researchers at the Institute of Vegetables and Flowers of Shandong Academy of Agricultural Sciences in Jinan, east China's Shandong Province, Jan. 7, 2022. In 2016, Ali, a Pakistani student at that time, came to China and got his doctor's degree at the Institute of Vegetables and Flowers of Chinese Academy of Agricultural Sciences. In 2021, he came to Jinan for further study, conducting his post-doctoral research here. "Shandong is a major agricultural province in China, which also has the edge on agricultural technology," said Ali. He hopes to bring the advanced vegetable planting technology he has learned here back to Pakistan to help develop the agricultural industry of his homeland. Ali is glad that he can witness and disseminate China-Pakistan friendship with vegetable sciences. (Xinhua/Guo Xulei)
Dr. Anwar Ali ckecks the growth of tissue culture vegetable he cultivated at the Institute of Vegetables and Flowers of Shandong Academy of Agricultural Sciences in Jinan, east China's Shandong Province, Jan. 7, 2022. In 2016, Ali, a Pakistani student at that time, came to China and got his doctor's degree at the Institute of Vegetables and Flowers of Chinese Academy of Agricultural Sciences. In 2021, he came to Jinan for further study, conducting his post-doctoral research here. "Shandong is a major agricultural province in China, which also has the edge on agricultural technology," said Ali. He hopes to bring the advanced vegetable planting technology he has learned here back to Pakistan to help develop the agricultural industry of his homeland. Ali is glad that he can witness and disseminate China-Pakistan friendship with vegetable sciences. (Xinhua/Guo Xulei)

Dr. Anwar Ali smells a plant at the Institute of Vegetables and Flowers of Shandong Academy of Agricultural Sciences in Jinan, east China's Shandong Province, Jan. 7, 2022. In 2016, Ali, a Pakistani student at that time, came to China and got his doctor's degree at the Institute of Vegetables and Flowers of Chinese Academy of Agricultural Sciences. In 2021, he came to Jinan for further study, conducting his post-doctoral research here. "Shandong is a major agricultural province in China, which also has the edge on agricultural technology," said Ali. He hopes to bring the advanced vegetable planting technology he has learned here back to Pakistan to help develop the agricultural industry of his homeland. Ali is glad that he can witness and disseminate China-Pakistan friendship with vegetable sciences. (Xinhua/Guo Xulei)
Photos
Related Stories
- CPEC serves as flagship of development strategy of Pakistan: minister
- Pakistan adds 358 COVID-19 cases, 2 more deaths
- CPEC's 2nd phase to expedite socio-economic development of Pakistan: official
- Pakistan reports 357 new COVID-19 cases, 7 more deaths
- Pakistan needs national data security strategy to meet cyber-attack challenges: president
Copyright © 2022 People's Daily Online. All Rights Reserved.









